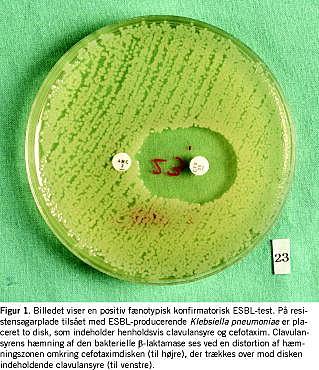

Enterobakterier (»gramnegative tarmbakterier«), som producerer extended spectrum β-lactamase (ESBL) ses med stadig større hyppighed i helt almindelige prøver fra både almen praksis og hospitaler. ESBL-enzymerne giver behandlingsproblemer da de kan nedbryde de fleste af vores vigtige β-laktam-antibiotika, såsom ampicillin, 1.-3.-generations-cefalosporiner (f.eks. cefalotin, cefuroxim og ceftriaxon) og aztreonam [1]. De fleste ESBL-enzymer hæmmes af β-laktamase-hæmmeren clavulansyre, hvilket udnyttes i de test, som anvendes på de mikrobiologiske laboratorier (Figur 1 ).
Kort tid efter introduktionen af tredjegenerationscefalosporinerne kom i begyndelsen af 1980'erne de første rapporter om resistente bakterier . Disse har siden bredt sig, således at 30-50% af enterobakterier isoleret på intensivafdelinger i mange sydeuropæiske lande nu er ESBL-producerende og tillige ofte også aminoglykosid- og quinolonresistente.
De første ESBL-enzymer var mutationer af TEM-1, det enzym der almindeligvis giver ampicillinresistens hos bl.a. Escherichia coli, og af SHV-1, et Klebsiella pneumoniae -enzym, som også giver ampicillinresistens. Med udgangen af 2005 er der beskrevet 144 TEM-enzymer og 70 SHV-enzymer [2]. I løbet af de sidste ti år er ESBL-familietræet blevet udvidet med endnu to grupper af enzymer, OXA- og CTX-M-enzymerne. OXA-enzymerne har endnu ikke forvoldt store problemer, men CTX-M-enzymerne er på hastig fremmarch; fra Storbritannien, Frankrig og Spanien rapporteres der om kraftig vækst i antallet af isolerede tilfælde, og selv fra et lavresistensområde som Sverige er der beskrevet udbrud. Med CTX-M-enzymernes fremkomst har epidemiologien ændret sig; hvor der tidligere oftest sås infektioner hos hospitaliserede patienter med SHV/TEM-producerende K. pneumoniae -isolater, ses nu oftere komplicerede urinvejsinfektioner hos almen praksis-patienter, som er inficerede med CTX-M-producerende E. coli .
I Danmark har man fra midten af 1990'erne lejlighedsvis fundet ESBL-producerende enterobakterier, ofte i forbindelse med overflytning af patienter fra højendemiske områder (Frankrig, Spanien, Grækenland, Tyrkiet, Thailand, Filippinerne m.fl.). Udvikling herhjemme ligner formentlig den ovenfor beskrevne, men gode tal herfor foreligger ikke. Blandt 380 konsekutive urinisolater indsamlet i 2003 på H:S Hvidovre Hospital påviste man en prævalens af ESBL-producerende E. coli på 1,3% [3]. Foreløbige undersøgelser af 46 danske ESBL-producerende isolater fra 2002-2003 viser, at 80% af disse havde CTX-M-enzymer.
Generne, der koder for ESBL-enzymerne, sidder oftest på plasmider, og smitte kan derfor ske, både ved at bakterien spreder sig mellem patienter (og personale), og ved at plasmidet med resistensegenskaberne spreder sig til andre bakteriearter. Generelt bør hospitaliserede patienter med ESBL-producerende bakterier isoleres for at forhindre smitte/kolonisation af medpatienter og personale [4].
Banale infektioner med ESBL-producerende bakterier kan behandles med kombinationen piperacillin og β-laktamase-hæmmer, mens alvorligere infektioner kan behandles med et carbapenem. Aminoglykosider og quinoloner kan anvendes efter forudgående resistensbestemmelse.
Korrespondance: Dennis Schrøder Hansen, Klinisk Mikrobiologisk Afdeling, Hillerød Sygehus, DK-3400 Hillerød. E-mail: dsh@ssi.dk
Interessekonflikter: Ingen angivet
<ol class="Litt-list">
<li>Bradford PA. Extended-spectrum beta-lactamases in the 21st century: characterization, epidemiology, and detection of this important resistance threat. Clin Microbiol Rev 2001;14:933-51.</li>
<li>http://www.lahey.org/studies /dec. 2005.</li>
<li>Jensen HN, Hansen DS. Prævalensen af ESBL-producerende E. coli- og Klebsiellastammer på Hvidovre Hospital. Nyt om Mikrobiologi, nr. 66, 2005.</li>
<li>Paterson DL, Yu VL. Extended-spectrum beta-lactamases: a call for improved detection and control. Clin Infect Dis 1999;29:1419-22.</li>
</ol>